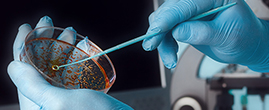

Reliance Industries Ltd. and SIBUR have forged a partnership to seize the opportunities within the robustly growing synthetic rubber industry.

South Asia's First halogenated Butyl Rubber unit at jamnagar
Construction Begins on RSEPL Butyl Rubber Plant
Butyl rubber is a synthetic polymer, a copolymer of isobutylene with isoprene. The key advantages butyl rubber offers is superlative air-barrier performance with superior flex properties.